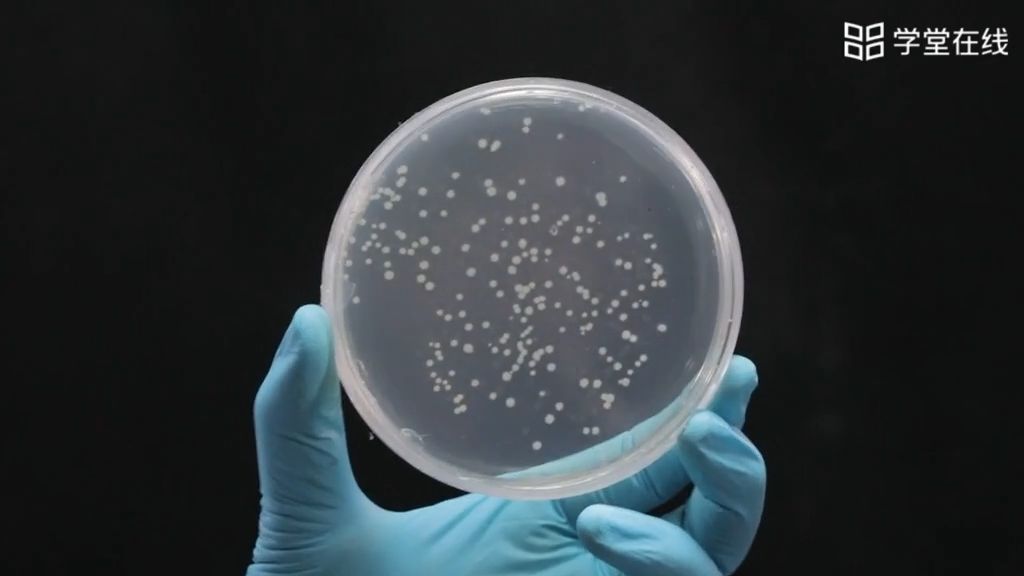
大肠杆菌感受态细胞的制备,质粒的转化及质粒dna的提取 - 哔哩哔哩

大肠杆菌质粒

环保检测饭 - 知乎
图片尺寸621x249
微生物实验二细菌的简单染色和革兰氏染色ppt_word文档在线阅读与下载
图片尺寸1080x810
【趣味模式生物】与人类「互惠共生」的大肠杆菌 - 知乎
图片尺寸600x450
【涨姿势】圆环,蓝耳也能造成猪腹泻
图片尺寸582x742
大肠杆菌细胞中都有质粒dna对吗?答案说不对,但是我记得基因工程那还
图片尺寸360x480
大肠杆菌涂片 细菌类生物玻片 单张可选-阿里巴巴
图片尺寸628x429
大肠杆菌nissle1917-sfgfp - 工程菌菌株 - 质粒/菌株 - 宝赛质粒菌株
图片尺寸699x784
大肠杆菌感受态细胞的制备,质粒的转化及质粒dna的提取 - 哔哩哔哩
图片尺寸1024x576
pdrive大肠克隆质粒 - 中贸网
图片尺寸980x827
人工构建的大肠杆菌质粒pbr322是基因工程中应用最广泛的载体.除标注
图片尺寸380x230
大肠杆菌显色培养基-培养基配方
图片尺寸650x650
质粒转化大肠杆菌ppt_word文档在线阅读与下载_无忧文档
图片尺寸1080x810
什么是尿频,意味着肾虚吗?健康排尿的衡量标准有哪些?特别注意
图片尺寸977x1200
质粒转化大肠杆菌实验-20210406170315.ppt-原创力文档
图片尺寸1152x864
微生物学实验课
图片尺寸1080x809
求各种细菌的显微镜图片 - 兽医交流/实战/药理区 - 鸡病专业网论坛
图片尺寸1280x1024
质粒- 搜狗百科
图片尺寸277x243
浙科版生物选修一第一部分 实验1 大肠杆菌的培养和分离 课件 (共23张
图片尺寸720x540
大肠杆菌是敌是友?|胰岛素|菌落|richard lenski|大肠杆菌|肠道|培养
图片尺寸640x457
大肠杆菌镜检出丝状 - 微生物学和寄生虫学讨论版 - 专业医生社区,医
图片尺寸4608x3456